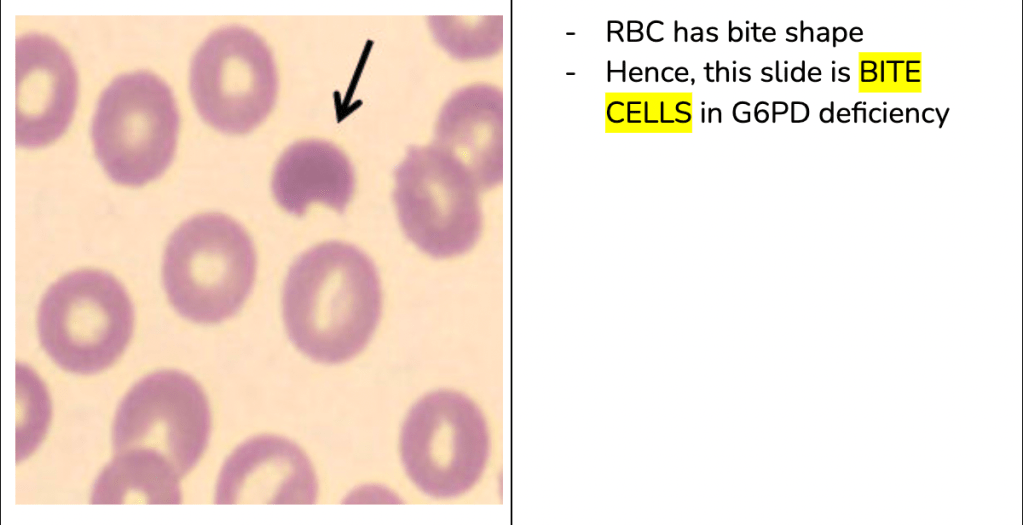

Reference: 1.shafers textbook 2.google
A complication of tonsillitis in which the infection spreads behind the tonsils.
A peritonsillar abscess occurs when a collection of pus forms and infection spreads beyond the tonsils into the neck and chest. Swollen tissues can block the airway.





















Sterilization refers to any process that removes, kills, or deactivates all forms of life and other biological agents like prions present in a specific surface, object or fluid, for example food or biological culture media.